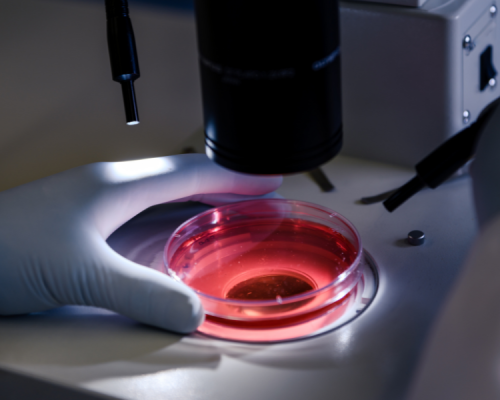
Cytology

Welcome to Sidharth
Chain of High Tech Diagnostics
Sidharth is one of Delhi’s leading, result-oriented diagnostic centre chains. Our first and principal centre is located in the heart of Delhi at 2169, Main Patel Road, West Patel Nagar, Shadipur, New Delhi–110008, near Metro Pillar No. 227, operating under the name Sidharth Diagnostic Centre & Sidharth CT Scan & Specialities. We take pride in having earned the trust of our patients through accuracy, dedication, and 44 years of diagnostic excellence.
We also operate additional diagnostic centres under the name Sidharth X-Ray Clinic at Rohini, Outer Ring Road, North Delhi–110085, and Sidharth Imaging & Diagnostic at Nangloi, Najafgarh Road–110041.
Between 1990 and 2000, we expanded our services to include Dialysis, ECHO, TMT, Ultrasound, and Holter monitoring under the name of our beloved father, Shri Ram Renal & Cardiac Centre, at the then BLK Memorial Hospital, Pusa Road, New Delhi–110005. In addition, we extended our diagnostic services for over five years at Parmarth Mission Hospital, Pitampura, New Delhi–110034.


We Employ Latest Research Technology & Company
“Viverra nec consectetur dictum at pulvinar ac ornare sed a fringilla integer varius metus ac, cras purus vulputate ultrices amet, sit porta hac mattis.”

Alex Hobbs,
Founder, CEO of PointLab
Our Facilities
Radiology & Imaging Services
Radiology

4D Ultrasound

Level II Ultrasound

Transvaginal Sonography

CT Scan

Colour Doppler Studies

Vascular & Venous Doppler Studies
Heart Station

2D Echo Cardiography

TMT (Treadmill Test)

ECG (Electrocardiogram)

Holter Monitoring
Neuro Physiology Station

EEG (Electroencephalography)

EMG (Electromyography)

NCV (Nerve Conduction Velocity)
Computerised Pathology Laboratory

Serology
Cytology

Haematology

ELISA Assays

Bio-Chemistry

Histopathology

Micro-Biology

Hormone Assays
4.8/5
1860 Reviews
4.6/5
1630 Reviews
4.7/5
2100 Reviews
Our Health Check-Up Packages
Thoughtfully designed health check-up packages to meet the needs of individuals, women, and senior citizens

Body Fit Panel
- USG – Upper Abdomen
- CBC (Complete Blood Count)
- Blood Urea
- Serum Creatinine
- SGOT & SGPT (Liver Enzymes)
- Serum Cholesterol
- Fasting Blood Sugar
- Triglycerides
- Urine R/M
- Stool R/M (By Concentration Method)

Senior Citizen Panel
- USG – Upper Abdomen
- Fasting Blood Sugar
- Complete Hemogram (Hb, TLC, DLC, ESR, PCV, MCV, MCHC, Platelet Count)
- Serum Creatinine
- Uric Acid
- Liver Function Test (SGPT, SGOT, GGTP, Bilirubin, Total Protein, Alkaline Phosphatase)
- Total Cholesterol
- ECG, Chest X-Ray

Healthy Women Panel
- USG – Lower Abdomen
- CBC
- Serum Creatinine
- Triglycerides
- SGPT
- Fasting & Post-Prandial Blood Sugar
- Urine R/M
- Stool R/M (By Concentration Method)
- Progesterone
- Thyroid Profile (FT3, FT4, TSH)

Premium Body Panel
- USG – Upper Abdomen
- Fasting Blood Sugar
- Liver & Kidney Function Tests
- Complete Hemogram (Hb, PCV, TLC, DLC, RBC Count, MCV, MCH, MCHC, Platelet Count)
- ESR (Westergren Method)
- Lipid Profile (Total Cholesterol, Triglycerides, HDL, LDL – Direct, VLDL – Calculated)
- ECG, Chest X-Ray
HEALTH WITH MEDICAL CARE
Sidharth – Chain of High Tech Diagnostics
PLATINUM HEALTH PACKAGE
- Homocysteine
- Vitamin D (25 Hydroxy)
- PFT (Pulmonary Function Test)
- KFT (Kidney Function Test)
- LFT (Liver Function Test)
- TFT (Thyroid Function Test)
- CBC (Complete Blood Count)
- Vitamin B-12
- Lipid Profile
- Blood Sugar
- Testosterone
- USG Upper Abdomen with Scrotum
- ECG
- Urine R/M
GOLD HEALTH PACKAGE (FEMALES)
- Homocysteine
- Vitamin D (25 Hydroxy)
- PFT (Pulmonary Function Test)
- KFT (Kidney Function Test)
- LFT (Liver Function Test)
- TFT (Thyroid Function Test)
- CBC (Complete Blood Count)
- Vitamin B-12
- Lipid Profile
- Blood Sugar
- Progesterone (Hormone)
- USG Lower Abdomen
- ECG
- Urine R/M
SILVER HEALTH PACKAGE
- PFT (Pulmonary Function Test)
- KFT (Kidney Function Test)
- LFT (Liver Function Test)
- TFT (Thyroid Function Test)
- CBC (Complete Blood Count)
- Lipid Profile
- Blood Sugar
- USG Upper Abdomen with Scrotum
- ECG
- Urine R/M
All results are professional opinion. Investigations are only a tool to facilitate in arriving at a diagnosis. Please correlate clinically in case of Opinion, Variation, Repeat or Discuss same day without any charges. Opinion is not valid for medico legal purpose. Thanks.
Our Expertise
40+ Years Trusted Experience
High-End Diagnostic Equipment
Trust on ISO Certified & Quality Assured Processes
X=ray Specialize
Specialized X-Ray & Imaging Services
Full-Fledged Pathology & Cardiac Lab
Diagnostic Centre
Complete Diagnostic & Imaging Services
Advanced Pathology & Cardiac Diagnostics
Our Centres
Sidharth Diagnostic Centre – Patel Nagar, Delhi
2169, Shadipur Main Patel Road, West Patel Nagar, New Delhi – 110008
Sidharth X-Ray Clinic – Rohini, Delhi: Sector-8, Pocket-A-III, MIG Flat No. 260, Outer Ring Road, Rohini, New Delhi – 110085
Sidharth Imaging & Diagnostic at Nangloi, Najafgarh Road–110041
Allergy Testing Services
Food Allergy (Vegetarian)
Food Allergy (Non-Vegetarian)
Inhalant Allergy
Contact Allergy
Drug Allergy
Combined Allergy Profiles
Why People Trust Us
Trusted Legacy Since 1982
Sidharth Diagnostics has been a trusted name in accurate and reliable diagnostic services.
High-Tech Infrastructure
We are equipped with state-of-the-art pathology and radiology equipment.
Accurate & Timely Reports
We understand the importance of timely diagnosis. Our expert team ensures high accuracy with fast report delivery, helping doctors and patients take prompt medical decisions.
Experienced Medical Professionals
Our diagnostic services are supported by qualified pathologists, radiologists, and trained technicians with years of experience in medical diagnostics.
What People Say About Us
We are proud to share real experiences from patients who rely on our accuracy, professionalism, and compassionate care for their diagnostic needs.

Rajesh K.
I have been visiting Sidharth Diagnostics for many years, and the accuracy of their reports has always been reliable. The staff is polite, and reports are delivered on time. Truly a trustworthy diagnostic centre.



Sidharth Lab Experts

DR. G. R. MALIK
M.B.B.S., M.A.G.S. (USA)
DIRECTOR (MEDICAL)

R. P. MALIK
B.S. CHEM (AGMARK)
DIRECTOR (ADM.)

DR. KARTIK MALIK
M.B.B.S.
Director

SANYAM MALIK (ADVOCATE)
LL.B (H), LL.M Solicitor (LONDON)
Director (Legal)
Get One Step Ahead Of Disease
We are here to assist you with appointments, test inquiries, reports, and general information. Reach out to us for reliable diagnostic services and prompt support from our team.
Subsribe To Our Newsletter
Stay in touch with us to get latest news and special offers.















